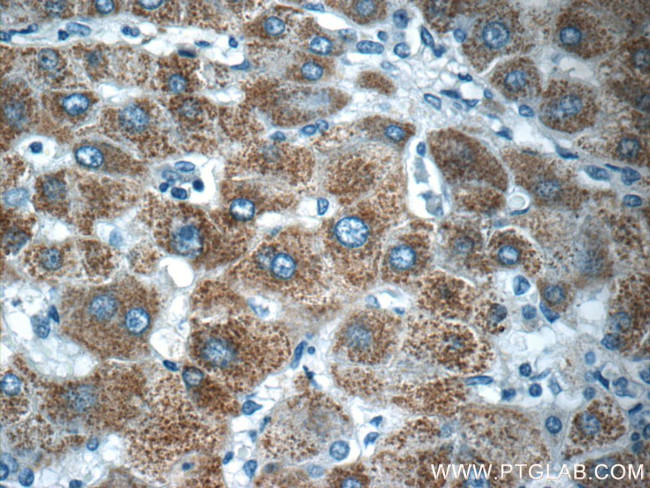
BMP9 Antibody in Immunohistochemistry (Paraffin) (IHC (P))

Search
Proteintech
BMP9 Polyclonal Antibody
{{$productOrderCtrl.translations['antibody.pdp.commerceCard.promotion.promotions']}}
{{$productOrderCtrl.translations['antibody.pdp.commerceCard.promotion.viewpromo']}}
{{$productOrderCtrl.translations['antibody.pdp.commerceCard.promotion.promocode']}}: {{promo.promoCode}} {{promo.promoTitle}} {{promo.promoDescription}}. {{$productOrderCtrl.translations['antibody.pdp.commerceCard.promotion.learnmore']}}
产品信息
17769-1-AP
种属反应
宿主/亚型
分类
类型
抗原
偶联物
形式
浓度
规格
纯化类型
保存液
内含物
保存条件
运输条件
产品详细信息
Immunogen sequence: KPLQSWGRG SAGGNAHSPL GVPGGGLPEH TFNLKMFLEN VKVDFLRSLN LSGVPSQDKT RVEPPQYMID LYNRYTSDKS TTPASNIVRS FSMEDAISIT ATEDFPFQKH ILLFNISIPR HEQITRAELR LYVSCQNHVD PSHDLKGSVV IYDVLDGTDA WDSATETKTF LVSQDIQDEG WETLEVSSAV KRWVRSDSTK SKNKLEVTVE SHRKGCDTLD ISVPPGSRNL PFFVVFSNDH SSGTKETRLE LREMISHEQE SVLKKLSKDG STEAGESSHE EDTDGHVAAG STLARRKRSA GAGSHCQKTS LRVNFEDIGW DSWIIAPKEY EAYECKGGCF FPLADDVTPT KHAIVQTLVH LKFPTKVGKA CCVPTKLSPI SVLYKDDMGV PTLKYHYEGM SVAECGCR (23-429 aa encoded by BC074921 )
靶标信息
The protein encoded by this gene is a member of the bone morphogenetic protein (BMP) family and the TGF-beta superfamily. This group of proteins is characterized by a polybasic proteolytic processing site which is cleaved to produce a mature protein containing seven conserved cysteine residues. The members of this family are regulators of cell growth and differentiation in both embryonic and adult tissues. Studies in rodents suggest that this protein plays a role in the adult liver and in differentiation of cholinergic central nervous system neurons.
仅用于科研。不用于诊断过程。未经明确授权不得转售。
篇参考文献 (0)
生物信息学
蛋白别名: BMP; BMP-9; Bone morphogenetic protein; Bone morphogenetic protein 9; GDF-2; Growth/differentiation factor 2; secreted protein; GDF-2; transforming growth factor-beta superfamily member; unnamed protein product
基因别名: BMP-9; BMP9; GDF2; HHT5
UniProt ID: (Human) Q9UK05
Entrez Gene ID: (Human) 2658